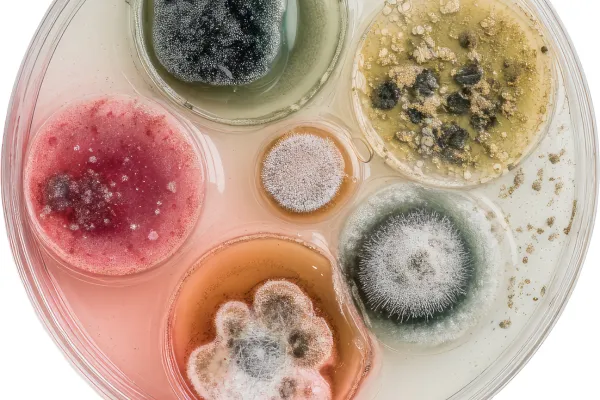
What Are the Different Types of Mold in a Home?

Who Pays for Mold Remediation?
If you’re dealing with mold, one of the first questions that comes up is: “Who actually pays for this?” Here’s the honest answer—no fluff, no guessing
➤ (888) 928-6653 ____ ➤ Schedule Inspection
Learn how to protect your home and Family

If you’re dealing with mold, one of the first questions that comes up is: “Who actually pays for this?” Here’s the honest answer—no fluff, no guessing

What is dry fogging? Discover how dry fogging mold remediation works and how does fogging work for mold removal.

Do landlords have to fix mold in rental properties? Understand mold landlord responsibility and when mold removal is required.
Different types of mold found in homes. Learn how many different types of mold are there and how to identify common mold types in home.

How to detect black mold in your home. Learn warning signs, where to look, and how to get rid of black mold before it spreads.

Does ammonia kill mold? Find out if it really works, what ammonia is, and better ways to kill mold in your home.
Copyright © 2026 ZeroMold. All Rights Reserved - Privacy Policy - Terms & Conditions